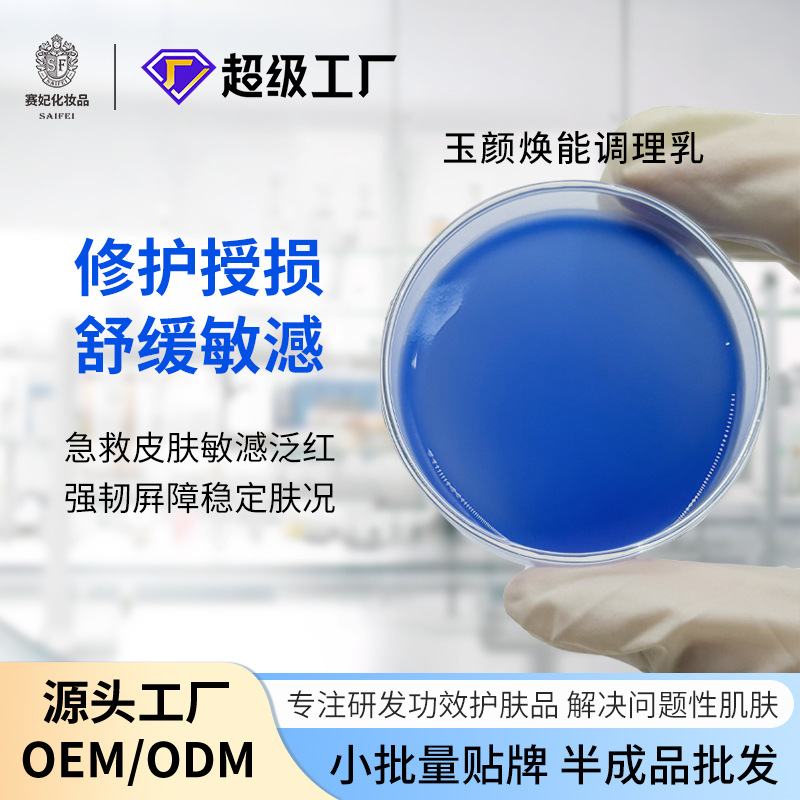

Показать еще
Товары поставщика: abb-b2b-2102187357
Задать вопрос
Заказ услуги
Заказать звонок
Избранное
Товары отсутствуют
Купить в 1 клик
Оставьте данные и наш оператор
свяжется с Вами
свяжется с Вами
Восстановить пароль